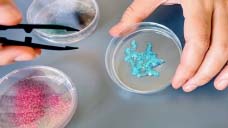

A new study has found tiny plastic particles in nine out of 10 men diagnosed with prostate cancer. Researchers also discovered that these microplastics were present at higher concentrations in cancerous tumors than in nearby noncancerous prostate tissue.The investigation was carried out at New York University (NYU) Langone Health, including its Perlmutter Cancer Center and Center for the Investigation of Environmental Hazards. The research team set out to explore whether exposure to microplastics could contribute to the development of prostate cancer, which the American Cancer Society identifies as the most common cancer among men in the United States.Plastic materials used in food packaging, cosmetics, and many everyday products can break down into microscopic fragments when heated, worn down, or chemically processed. These particles can enter the body through food, breathing contaminated air, or contact with the skin. Previous research has detected microplastics in nearly every organ, as well as in bodily fluids and even the placenta. Despite their widespread presence, scientists still do not fully understand how these particles may affect human health.The researchers examined prostate tissue collected from 10 patients undergoing surgery to remove the gland. Plastic particles were identified in 90 percent of tumor samples and in 70 percent of benign prostate tissue samples.The difference in concentration was notable. On average, tumor samples contained about 2.5 times more plastic than healthy tissue (about 40 micrograms of plastic per gram of tissue compared with 16 micrograms per gram).“Our pilot study provides important evidence that microplastic exposure may be a risk factor for prostate cancer,” said study lead author Stacy Loeb, MD, a professor in the NYU Grossman School of Medicine’s Departments of Urology and Population Health.Loeb noted that earlier research had suggested possible links between microplastics and conditions such as heart disease and dementia, but there had been little direct evidence tying them specifically to prostate cancer.The findings will be presented on Feb. 26 at the American Society of Clinical Oncology’s Genitourinary Cancers Symposium. According to Loeb, this is the first Western study to measure microplastic levels in prostate tumors and compare them directly with levels in noncancerous prostate tissue.To conduct the analysis, scientists first reviewed tumor and benign tissue samples under visual inspection. They then used specialized instruments to measure the quantity, chemical composition, and structure of microplastic particles. The team focused on 12 of the most common plastic molecules.Because plastic is widely used in medical and laboratory equipment, researchers took extra precautions to prevent contamination. They replaced plastic tools with alternatives made from aluminum, cotton, and other nonplastic materials. All testing was performed in controlled clean rooms designed specifically for microplastic analysis.“By uncovering yet another potential health concern posed by plastic, our findings highlight the need for stricter regulatory measures to limit the public’s exposure to these substances, which are everywhere in the environment,” said study senior author Vittorio Albergamo, PhD.Albergamo, an assistant professor in the NYU Grossman School of Medicine’s Department of Pediatrics, said the team plans to further investigate how microplastics behave inside the body and whether they may contribute to cancer formation. One possibility under consideration is that the particles trigger a prolonged immune response (inflammation) within prostate tissue. Over time, chronic inflammation can damage cells and cause genetic changes that lead to cancer.